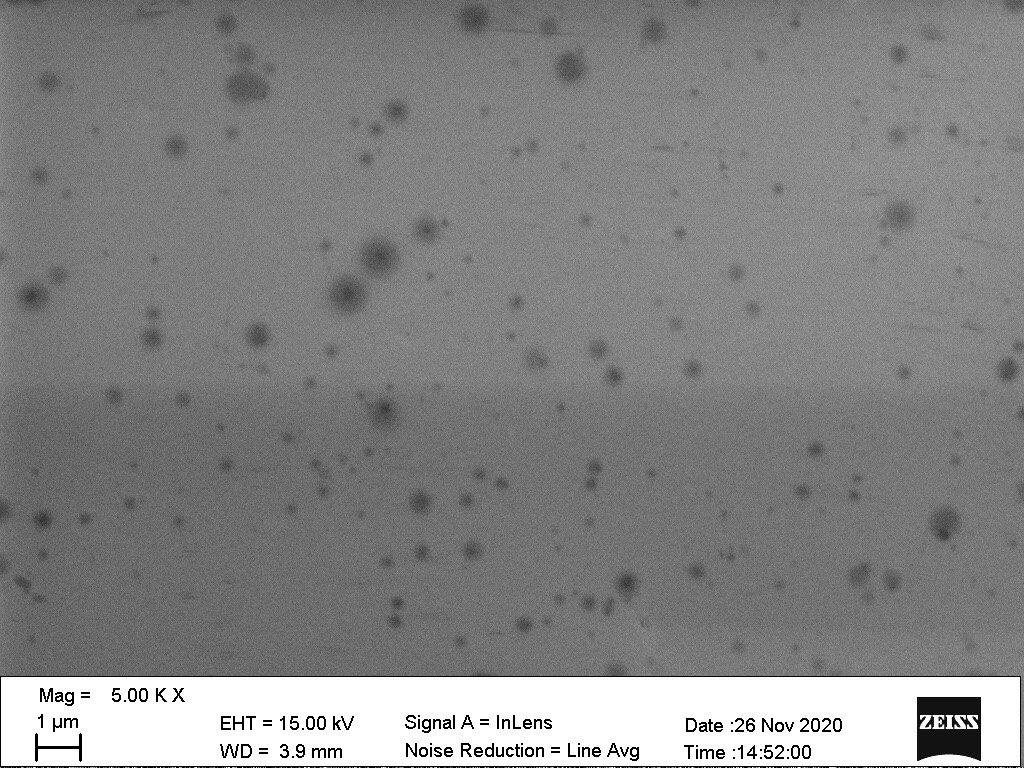

FlowVIEW Lab
Yogurt under SEM
Nanoscience in Life - Pectin
Introduction to Ingredients of Yogurt
 ▲Source: Unsplash
▲Source: Unsplash
What is "Pectin" ?
Pectin, a kind of natural polymer compounds, is one of the components of plant cell wall. It can make plant cells tightly stick together and is usually extracted from skin of fruits.
To human body, pectin is an indigestible water-soluble fiber.
To yogurt, however, pectin acts as the role of stabilizer, which can effectively avoid aggregation and precipitation of protein or whey separation.
The ester functional groups contained in pectin will generate bonds between pectin molecules, thus increase the thickness of yogurt; at the same time, pectin will also form bonds with water to improve the smoothness of yogurt.
▲Pectin under SEM
▲Pectin under SEM
Source : FlowVIEW
Three Benefits of Drinking Yogurt
• Can be alternatives to fresh milk
Yogurt is mainly fermented from milk and lactic acid bacteria. Therefore, it can provide all the rich nutrients contained in milk, like protein, calcium, vitamin B complex and minerals. As compared with milk, yogurt is easier to digest and absorb, leading to a higher bioavailability.
• Maintain functions of alimentary canal/ Strengthen immune system
The probiotics contained in yogurt can help improve the intestinal flora, making good bacteria more than bad ones. Lactic acid bacteria can make vitamin B complex in milk become richer through fermentation, and the nutrients will be turned into small molecules, making it easier for human body to absorb and less prone to flatulence. Besides, lactic acid bacteria can also strengthen the body's immunity by activating macrophages, stimulate the body's immune system to produce antibodies, and suppress the formation of tumors.
• Reduce the incidence of colon cancer
Through the action of lactic acid bacteria, yogurt can not only reduce the concentration of carcinogenic enzymes in the stool, but also reduce the production of carcinogens and the risk of cancer. Besides, the butyric acid, produced by the metabolism of intestinal lactic acid bacteria, also has the effect of inhibiting the proliferation and differentiation of tumors in the intestine.
Three Steps to Easily Choose Yogurt
1. Understand the nutrition labels. First, carefully look the description of ingredients, make sure you know what spices, pigment or additives are in it before purchasing.
2. Pay attention to expiration date. Check whether the products are expired or not. (The refreshing time of yogurt is usually two weeks.) Fresher products are better.
3. Know your own needs. Easily choose the most suitable yogurt according to your own needs and preferences!
Three Common Myths of Yogurt
Q: "Classic" yogurt, means no additives, no coloring or no flavoring? Is yogurt without preservatives healthier?
A: In fact, many white yogurts on the market meet CNS3058 standard, which means that they are actually "flavored fermented milk" rather than real classic yogurt. Therefore, you still need to follow the ingredient description while purchasing.
Besides, yogurt is originally forbidden to use preservatives in the manufacturing process. Therefore, "Yogurt without preservatives" is just a marketing technique. Don't be fooled!
Q: Drink milk will make me have diarrhea. Will I be okay to be yogurt?
A: The "lactose" in milk is the chief culprit for diarrhea after drinking milk. During the fermentation of yogurt, not only does lactose turn into lactic acid and other organic acids, but also the lactic acid bacteria will produce a large amount of "lactase", helping the body break down lactose. Therefore, patients who generally suffer from lactose intolerance can consider drinking yogurt to take in similar nutrients!
 ▲Source: Unsplash
▲Source: Unsplash
Q: Can infants and young children drink yogurt?
A: Infants under 1 year old are in the developmental stage, their digestive system is weak, and the microbial flora is also in the changing stage, which is relatively unstable; if they drink cold yogurt at this time, it may cause imbalance of intestinal flora, affecting digestion and absorption, and even cause intestinal diseases. Therefore, drinking yogurt is less recommended.
Infants over 1 year old, due to the well-developed digestive system, are less allergic to milk protein, so they can drink yogurt in moderation; it is recommended to choose products with high calcium and low sugar content, and take 400cc per day as a maximum benchmark.
 ▲FlowVIEW Lite Image Analysis Software
▲FlowVIEW Lite Image Analysis Software
Source: FlowVIEW
FlowVIEW Lite Image Analysis Software
FlowVIEW Lite Image Analysis Software is our self-developed software. It is capable of analyzing wet samples automatically, generating essential data such as particle shape, size distribution, dispersity/composition, etc.
You can choose MIPAR to receive more accurate results regarding the overlapping of aggregated bubbles. MIPAR is an image analysis software designed exclusively for material scientists. It is capable of identifying and measuring image features and generating results quickly.